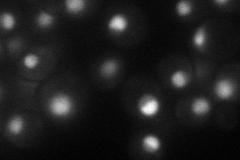
YPL082C
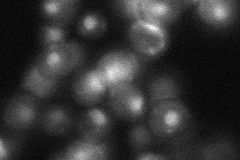
YPL082C

View description
Essential abundant protein involved in regulation of transcription, removes Spt15p (TBP) from DNA via its C-terminal ATPase activity, forms a complex with TBP that binds TATA DNA with high affinity but with altered specificity
Localization:
Intensity:
Fold change:
Significance:
-
C’ GFP library in SD

nucleus77.74 -
N' NOP1pr-GFP in SD
nucleus,nucleolus52.8213 -
N' TEF2pr-mCherry in SD

missing0 -
N' NATIVEpr-GFP in SD
nucleus23.6142 -
N' TEF2pr-VC and Cyto-VN in SD

#N/A0 -
C’ GFP library in SD+DTT

nucleus52.010.66No -
C’ GFP library in SD+H2O2

nucleus91.81.18No -
C’ GFP library in Starvation Media

nucleus47.610.61Yes -
C’ GFP library on the background of Pup2-DaMP

nucleus -
C’ GFP library on the background of CCT mutant

nucleus79.61241.024No
